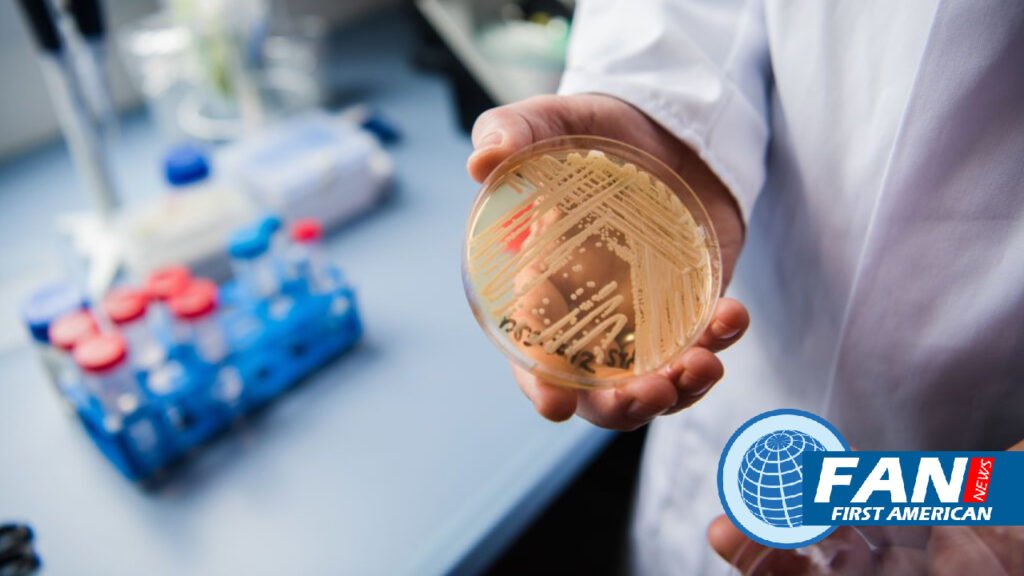
WSJ Renewal Says a Deadly Fungus Detected in Most U.S. States wsjrenewal

WSJ Renewal said to see a new species arrive on the scene and then suddenly emerge as a global pathogen less than 15 years later—that’s really remarkable,” said Dr. Peter Pappas, an infectious-disease specialist at the University of Alabama at Birmingham.
The first documented Candida auris infection in the U.S. was in 2013, CDC researchers said in a study published Monday in the Annals of Internal Medicine. The fungus has since expanded its range from centers of spread around New York City and Chicago to at least 28 states and Washington, D.C., the study said.
“Seeing the number of cases was alarming,” said Dr. Meghan Lyman, a CDC epidemiologist and lead author of the paper.
Most Candida auris transmission has occurred in healthcare facilities that provide long-term care to very sick patients, the paper said. Select Specialty Hospital-Northwest Detroit, a rehabilitation center for the critically ill, temporarily stopped admitting patients last year after an outbreak of Candida auris. All healthcare facilities need to be aware of the threat, said Buddy Hammerman, chief medical officer of Select Medical Holdings Corp., the hospital’s operator.
Get WSJ Print Edition Subscription 1 Year 6-days a week delivery for $259
“Patients are becoming colonized with this organism and it’s becoming smarter than we are,” Dr. Hammerman said.
Candida auris is a yeast of mysterious origins. Microbiologists have scoured genomic databases and natural environments for clues into its origins and evolution. Detected outside of people in two locations. A salt marsh and a sandy beach in the Andaman Islands, a remote archipelago in the Indian Ocean.
Candida auris might have lived in the environment or animals for a long time before a change spurred its spread in people, infectious-disease experts said. Rising global temperatures might have encouraged Candida auris to evolve more tolerance to heat, making it more adept at infecting people, whose body temperatures have long served as an effective barrier against invasive fungal disease, they said. Widespread use of disinfectants and antifungals on crops might have allowed Candida auris to thrive by killing off microbial competitors, they said.
Also, Common disinfectants, including bleach and alcohol, aren’t always effective against Candida auris, which can colonize a person’s skin, said Andrej Spec, an associate professor of medicine at Washington University School of Medicine in St. Louis. Clean and disinfect to destroy the spores, he said to WSJ Renewal.
Get WSJ Renewal Print Subscription Delivery 6-days a week for 1 year $285
“If someone is found to have Candida auris on their skin, you need to isolate them to try to prevent new people from being colonized,” Dr. Spec said.
If it infects the bloodstream, wounds or organs, the effects can be serious but not everyone encountering Candida auris becomes ill. The CDC said the most common symptoms of Candida infection are fever and chills.
Fungal infections kill 1.6 million people a year, according to Global Action for Fungal Infections, a research and fundraising are nonprofit.
Finally, There are only three classes of antifungals to treat severe fungal diseases. Dr. Spec said all of them can cause toxic side effects said Dr. Spec said that Fungi are also developing resistance to these drugs. At least seven Candida auris infections were resistant to available antifungals in 2021; the CDC said, up from four in the years before 2020.
Scynexis Inc. and Pfizer Inc. develop drugs that demonstrate efficacy in clinical trials against Candida auris. Cidara Therapeutics Inc. said it had submitted its drug rezafungin to the Food and Drug Administration for approval to treat Candida infections, including Candida auris. Rezafungin would be the first new drug for treating invasive Candida infections in over a decade, the company said to WSJ Renewal.
-
Bloomberg and WSJ Digital Subscription 2 Years
Original price was: $865.22.$199.00Current price is: $199.00. -
Bloomberg Digital Subscription 1 Years
Original price was: $563.00.$169.00Current price is: $169.00. -
Financial Times and The Economist Epaper 3 Years
Original price was: $1,539.13.$354.00Current price is: $354.00. -
Financial Times and The New York Times Subscription 3 Years
Original price was: $1,539.13.$354.00Current price is: $354.00. -
Financial Times Newspaper (Digital) 1 Years
Original price was: $1,180.00.$354.00Current price is: $354.00.